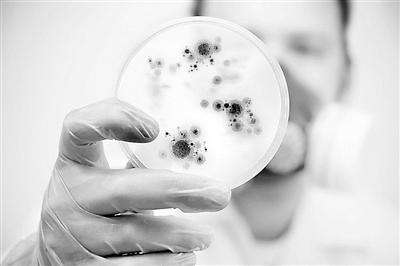
细菌群能驱动3D打印 | 医学科普

据外媒“工程学”官方网站日前报道,罗马大学物理学教授罗伯托·列奥纳多开发出一系列微型电机,用细菌和激光就能供能,并开始转动。相关研究论文已发表在《自然通讯》杂志上。
纳米级的3D打印技术已不新鲜,但相关应用仍不断推陈出新。其中一种名为“双光子光刻”的技术成为流行之后,许多审美模型的制作都采用了该技术,包括微观赛车、航天飞机,甚至古罗马雕塑等。
虽然,研究人员也希望将这项技术应用于医学领域,然而到目前为止,从机械的角度来看,成效有限。例如,一个研究小组就曾用3D打印制成名为“鲨鱼”的纳米设备,能在磁场中自由移动,其他研究小组则致力于开发新的几何形状,以提高靶向递送药物的成功概率。
过往研究的确证明了纳米技术在某些应用中有巨大潜力,打印出的对象具有出人意料的医学疗效。而罗马大学的科学家则利用此特性,开发出由光控细菌供能的微型电机。在实验中,列奥纳多的团队展示了36个电转机是如何运转一致,预示了3D打印微机械的未来是什么样。
列奥纳多表示,利用纳米技术和微细加工等现代工具,研究者能制作出越来越好的微型机械。通过3D打印的双光子光刻系统,任何形状都能打印出来,但想要机械能自主运动,就需要找到动力。用半固态树脂制作出的机械系统,配合全息光镊等装配工具,就能利用激光操纵微小生命体。
列奥纳多实验团队推出的特殊电机中,研究者使用了基因工程修正过的大肠杆菌。在微型电机阵列中,每个电机外表上都被蚀刻有15个微室,当研究者滴入一滴包含数千游动的细菌后,它们会一个个游入微室中,头部在内,鞭毛在外。在合力作用下,细菌变成了微小的“螺旋桨”,像流水转动水车一样,转动3D微型电机。
由于改造后的大肠杆菌也有自己的游泳方式和行为特点,所以研究者还特意在电机上建立了小小坡道,用45度角倾斜,使扭矩最大化,将其赶进微室,让鞭毛在腔室外面自如鞭打,推动单个电机转子运动。但这方法的缺陷在于,细菌产生的推力是间歇性的,马达旋转1次耗时大约1分钟,有时候一些转子的运动方向还会反向,白白耗力。
为了聚集和控制细菌,研究者每隔10秒就用激光点亮一次电机系统,从而使系统内每个组件都能步调一致。过去,科学界惯常使用电场或磁场来控制细菌,但造价高昂,不易制成。而用光控制电机系统,操作简单且成本低,也能让细菌对环境中的不同信号做出目标反应。
列奥纳多指出,生命的基本单位是细胞,医学诊断可以从收集单个细胞开始。目前人类的研究还只是个开始,独立研究者总是在物理、工程、生物等领域不懈努力,但从纳米技术的角度看,不同领域的研究放在一起,社会才能获得最大益处。
Copyright 2020 yaoxie.com 互联网药品信息服务资格证书(闽)-经营性-2019-0023 互联网药品交易服务资格证书-国A20150004
闽ICP备14018699号-4 增值电信业务经营许可证 闽B2-20140006 闽公网安备35030502000131号 营业执照:91350300056126227U
医疗器械网络交易服务第三方平台备案凭证 备案编号:(闽)网械平台备字(2018)第00001号
药品网络交易第三方平台备案凭证 (闽)网药平台备字 (2023) 第000004-000号